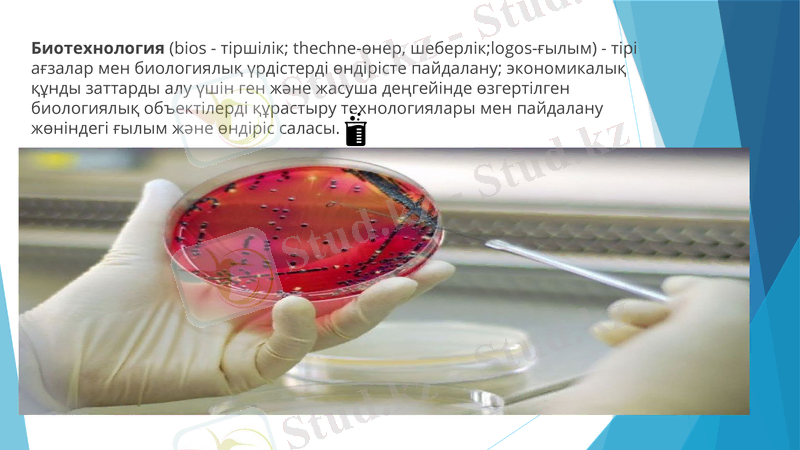
Slide 8

Нанобиотехнология мен биотехнология: ұғымдар, үдерістер және қолданбалар



ПРЕЗЕНТАЦИЯ
Тақырып:Нанобилтехнология
Орындаған:Сейілхан. Ә
Топ:ЖМҚА-0622А
Қабылдаған:Сейдалиевна. Г

Мазмұны 1Кіріспе 2Негізгі бөлім 1. 1Нанобиотехнологияның анықтамасы. 1. 2Нанобиотехнология үдерістері. 2. 1Биотехнологиялық үдерістердің негізгі кезеңдері. 2. 2Нанобиотехнология жетістіктері. Қортынды Пайдаланылған әдебиеттер Глоссарий

Нанобиотехнология - Нано миллиард есе кішірейген дегенді бідіреді (nannos) грек тілінің ергежейлі сөзінен алынған, биотехнология (ағылшынша“nanobiotechnology”) биология және технологиялық жолдар- дың кең шеңберін қамтитын нанотехнологияның тоғысқан жерiн-дегi ғылымның облысы мен қоса: биотехнологиядағы технологиялық құрылымдар және материалдарының қолдануы; биологиялық молекула-ларды нано технологиялық мақсаттар үшiн қолдану қасиетi.

(өлшемi дипазоне 1 100 нмге жататын объекттер үшiн) өлшемдi анықтала-тын биотехнологиялық өнiмдердiң жасауы негiзiнде нано құрылымдардың өздiгiнен ұйымдасу қағидаларын тексеру, биотехнологиялық жолдарды қолдану. Биологиялық макромолекула-лардың өлшемдері - (днқ, рнк) нуклеин қышқылдары. Мысал: металлдар-дың бөлшектiң биогендiк емес табиғатының Нанообъектысы немесе жартылай өткiзгiш кванттық нүктелер нақтылы биологиялық нысаналарға мақсаттық әсер үшiн қолайлы макромолекулалардың сақтаушы бола ала-ды.


Нанотехнологиялық үдерістер жеке атомдарды молекуланың бөлшектері ретінде қарастырып және пайдаланып ерекше қасиеттер мен қызметтерге ие жаңа құрылымдарды құрастыру әдістерін іздестіруде.
Нанотехнологияларды көптеген ғылым және өндіріс салаларында қолдануға болады. Мысалы; нанотехнологияларды медицина қолдану қажеттілігі-ішкі мүшелердің қызметтеріне мониторинг жасау үшін қажет болса оларды молекулалық деңгейде өзгертіп жөндеу мақсатында, яғни молекулалық

операцияларды жүзеге асыру мақсатында, дәрі-дәрмектерді жасушаларға дәл және бағытты тасымалдау үшін қолдануға болады.
Қазіргі кездегі нанотехнологиялық зерттеулер негізінен дәрі-дәрмек заттарды зақымдалған жасушаларға дәл жеткізу үшін, нанотасымалдаушыларды құрастыруға бағытталған.
Қазіргі кезде кейбір ғылыми ұжымдар компаниялар нанотехнологиялық үдерістер нәтижесінде ерекше роботтарды - нанороботтарды құрастыруға қол жеткізді.
Биотехнология (bios - тіршілік; thechne-өнер, шеберлік; logos-ғылым) - тірі ағзалар мен биологиялық үрдістерді өндірісте пайдалану; экономикалық құнды заттарды алу үшін ген және жасуша деңгейінде өзгертілген биологиялық объектілерді құрастыру технологиялары мен пайдалану жөніндегі ғылым және өндіріс саласы.

Биотехнологияның негізгі объектісі - тірі жасушалар, этап айтқпанда жануар, өсімдік текті жасушалар және микробтар немесе олардың биологиялық белсенді метаболиттері. Биотехнологияның мақсаты өсімдіктердің жаңа сорттарын, жануарларды асыл тұкымын, микроорганизмдердің штаммаларын шығару.

Биотехнологияның негізгі объектісі тірі жасушалар, атап айтқанда жануар, өсімдік текті жасушалар және микробтар немесе олардың биологиялық белсенді метаболиттері.
Биотехнологияның міндеттері: - әр түрлі биотехнологиялық өнімдердің өндіріс сұрақтарын шешу және жаңа биотехнологиялық үрдістерді дамыту; - энергияның альтернативтік көздерін алу; тағам өнімдерінің биотехнологиясы; - биологиялық белсенді заттар және антибиотиктердің синтезі; - қоршаған орта жағдайының биологиялық индикаторларын құру және іздеу; - микроорганизмдер, өсімдіктер және жануарлардың селекциялары

Гендік инженерия
Соңғы жылдары молекулалық биология мен генетика ғылымдарының жетістіктеріне байланысты гендік инжерения ғылымы пайда болды. Гендік инженерияда бір организм геномынан қажетті генді бөліп алып оны басқа организмнің геномына енгізу әдісі қолданылады. Гендік инженерия организмдердің жаксы қасиеттерін сақтап қалумен қатар оған сапалы қасиет бере алады. "Инженерия" термині құрастыру деген мағынаны білдіреді. Гендік инженерияның мақсаты - алдын ала белгіленген үлгіге сәйкес генотипі жағынан жақсарған организмдер алу. Алғаш рет гендік инженерияның тәсілдерін пайдаланып инсулин алды. Инсулин гормоны адамның ұйқы безінде жасалынады. Егер инсулиннің түзілуі бұзылатын болса, адам диабет ауруына шалдығады.

Биотехнологияның бағыттары Жасушалық инженерия Гендік инженерия Экологиялық инженерия Инженерлік экзимология Микробиологиялық өндіріс

Жасушалық инженерия:
Жасушалық инженерия гибридизация, реконструкция және қолдан өсіру негізінде жасушалардың жаңа түрлерін алу әдісінде қолданылады. Жасушалық инженерия жоғары сатыдағы организмдердің, өсімдіктер мен жануарлардың жеке жасушаларын және ұлпаларын жасанды көректік орта жағдайында өсіру. Жасушалық инженерия әдісі арқылы бір жасушаның ядросын екінші жасушаға көшіру және ядросыз жасушаларды өсіріп алуға болады. Жасаңды көректік ортада, яғни "in vitro" (жасанды) жағдайында жануарлардың (ит пен мысықтың, тышқан мен адамның) гибридтік жасушасын алған.


Бүгінгі биотехнология жетістіктері мал азығының сапасын арттыратын отандық “Казбиосил” препаратын атасақ болады. Жылдан-жылға жайылымдар мен шабындықтардың жетіспеушілігінен мал азығын дайындау мәселесі қиынға соғып отырған шақта, аталмыш препараттың пайда болуы нәтижесінде түкке жарамсыз болып қалған жерлердің құнарлылығын қайта қалпына келтіріп, қоршаған ортаның саламаттылығын арттыруға мүмкіндік тудырып отыр . Мұнымен шектелмей, сүрленген

азықтың қажеттілігі артып, ірі қаралардың өнімінің артуына ықпалын тигізуде. Бұл-биотехнологияның адамзатқа тигізер пайдасын білдіреді емес пе?
Сонымен қатар, Ұлттық биотехнологиялық орталық Қазақстанда алғаш рет құс тұмауына қарсы «Қазақстан - 15» ауыл шаруашылығы вакцинасын жасап шығарғанын айтпасқа болмас. . Бұл қазақстандық ғалымдарымыздың ғылыми саладағы үлкен жетістіктерінің бірі болды.

медициналық және фармацевтикалық биотехнологияда әлі күнге дейін сұраусыз, жергілікті жабайы өсетін флораның перспективалық түрлерінің зерттеу нысаны болып табылатындығымен анықталады. Оңтүстік өңірдің жабайы өсетін флорасының биотехнологиялық потенциалын зерттеу және өсімдік экстрактыларынан биопрепарат алудың бар технологияларын жетілдіру үлкен ғылыми қызығушылық тудырады, себебі, бұл нәтижелер өсімдік биомассасынан аса тиімді дәрілік заттарды бөліп алу және өсімдіктердің жаңа түрлерін қолдану мүмкіндіктері туралы мәліметтерді кеңейтеді.

- Іс жүргізу
- Автоматтандыру, Техника
- Алғашқы әскери дайындық
- Астрономия
- Ауыл шаруашылығы
- Банк ісі
- Бизнесті бағалау
- Биология
- Бухгалтерлік іс
- Валеология
- Ветеринария
- География
- Геология, Геофизика, Геодезия
- Дін
- Ет, сүт, шарап өнімдері
- Жалпы тарих
- Жер кадастрі, Жылжымайтын мүлік
- Журналистика
- Информатика
- Кеден ісі
- Маркетинг
- Математика, Геометрия
- Медицина
- Мемлекеттік басқару
- Менеджмент
- Мұнай, Газ
- Мұрағат ісі
- Мәдениеттану
- ОБЖ (Основы безопасности жизнедеятельности)
- Педагогика
- Полиграфия
- Психология
- Салық
- Саясаттану
- Сақтандыру
- Сертификаттау, стандарттау
- Социология, Демография
- Спорт
- Статистика
- Тілтану, Филология
- Тарихи тұлғалар
- Тау-кен ісі
- Транспорт
- Туризм
- Физика
- Философия
- Халықаралық қатынастар
- Химия
- Экология, Қоршаған ортаны қорғау
- Экономика
- Экономикалық география
- Электротехника
- Қазақстан тарихы
- Қаржы
- Құрылыс
- Құқық, Криминалистика
- Әдебиет
- Өнер, музыка
- Өнеркәсіп, Өндіріс
Қазақ тілінде жазылған рефераттар, курстық жұмыстар, дипломдық жұмыстар бойынша біздің қор #1 болып табылады.



Ақпарат
Қосымша
Email: info@stud.kz